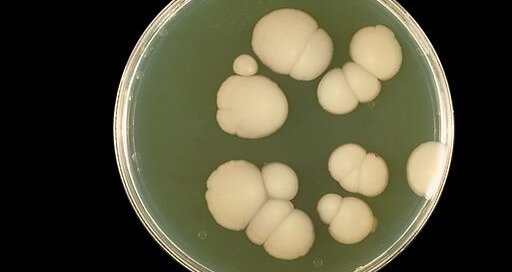
Dietary Control of Candida Overgrowth by Norm Robillard, Ph.D.

Can SIBO cause leaky gut?
Someone recently asked me if small intestinal bacterial overgrowth (SIBO) causes leaky gut, and if so, will the Fast Tract Diet help correct it?" SIBO is most definitely linked to leaky gut, and the connection goes a long way to explain why SIBO is linked to many autoimmune conditions including: Celiac disease Hashimoto’s Rheumatoid arthritis [...]